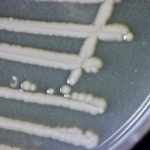

The federal opposition New Democrats are asking for an emergency debate in the House of Commons on the pending sale of majority control in CWB, the former Canadian Wheat Board. Winnipeg Centre MP Pat Martin, the party’s critic for public works and government services, announced Friday he has written to Commons Speaker Andrew Scheer requesting […] Read more

Opposition seeks Commons debate on CWB sale

More acres this spring for nearly all crops: AAFC
Canadian farmers are expected to take area out of summerfallow this spring for more acres of almost all major grains, oilseeds, pulses and special crops, the federal agriculture department said Friday. Canada’s total 2015-16 crop production is forecast to rise, due mainly to higher seeded area, due in turn to lower area in summerfallow and […] Read more
Rules planned to rein in antibiotic use for livestock
Health Canada is making its first move on new regulations to limit livestock producers’ own-use imports of veterinary drugs, and to tighten veterinary oversight of medicated livestock feed and water. Proposed changes to the federal Food and Drug Regulations and Feeds Regulations, announced Friday, tie into Health Minister Rona Ambrose’s federal action plan on antimicrobial […] Read more

Leafy greens eyed in E. coli outbreak
Federal health officials suspect leafy greens as a possible culprit in sickening 12 people in Canada, mainly in Alberta, with E. coli poisoning. The Public Health Agency of Canada on Wednesday said it’s considering a “possible link” to greens, such as lettuce, spinach, chard, kale or arugula, in 12 cases of E. coli O157:H7 poisoning […] Read more

Canada blocks poultry, eggs from N.D., Wisconsin, Iowa
The list of U.S. jurisdictions from which travellers can’t bring live poultry, eggs or raw poultry products into Canada is now three states longer. The Canadian Food Inspection Agency on Tuesday announced new restrictions on such products from North Dakota, Wisconsin and Iowa, following confirmed cases of H5N2 avian flu this week at commercial poultry […] Read more

PMRA review calls for slim changes to glyphosate label
A federal re-evaluation of glyphosate’s health risks leaves the popular herbicide’s status unchanged in Canada — but proposes tweaks to the product label as a “risk-reduction” measure. Products containing glyphosate “do not present unacceptable risks to human health or the environment when used according to the proposed label directions,” Health Canada’s Pest Management Regulatory Agency […] Read more

From the Pampas to the Prairies, 1872-1885: Part 3
Reprinted from the June 1948 issue of Canadian Cattlemen
From the Pampas to the Prairies, 1872-1885: Part 3 C.D. LaNauze, Lacombe, Alta. The author’s father writing in a letter to the North West Mounted Police: ‘Fort Walsh via Fort Assiniboia, Montana, U.S.A., July 16, 1880. Here we are at last at Headquarters having had just a month’s journey from Sarnia, Ontario. We had steamed […] Read more

Ont. organic dairy co-op in creditor protection
The co-operative behind one of Canada’s biggest names in organic dairy goods is in creditor protection and aiming to negotiate new terms on the eight figures owing to its creditors and members. Organic Meadow Co-operative announced Monday it had filed for creditor protection “in order to complete a restructuring of its operations.” The company said […] Read more

Funds blocked from investing in Sask. farmland, for now
Saskatchewan’s government plans to take a closer look at its rules on investment in farmland, but will block such investments by pension funds and other “institutional” investors while the review is underway. The province said Monday it will soon run further consultations and a review of farmland ownership rules as now laid out under the […] Read more

Zone coverage set up around SW Ont. avian flu site
The only farm in Canada now in the midst of an avian flu cleanup is the centre of a new control zone, meant to limit the flu’s spread and keep Canada’s trading partners at ease. The Canadian Food Inspection Agency (CFIA) on Sunday announced it has set up an avian flu control zone, which so […] Read more